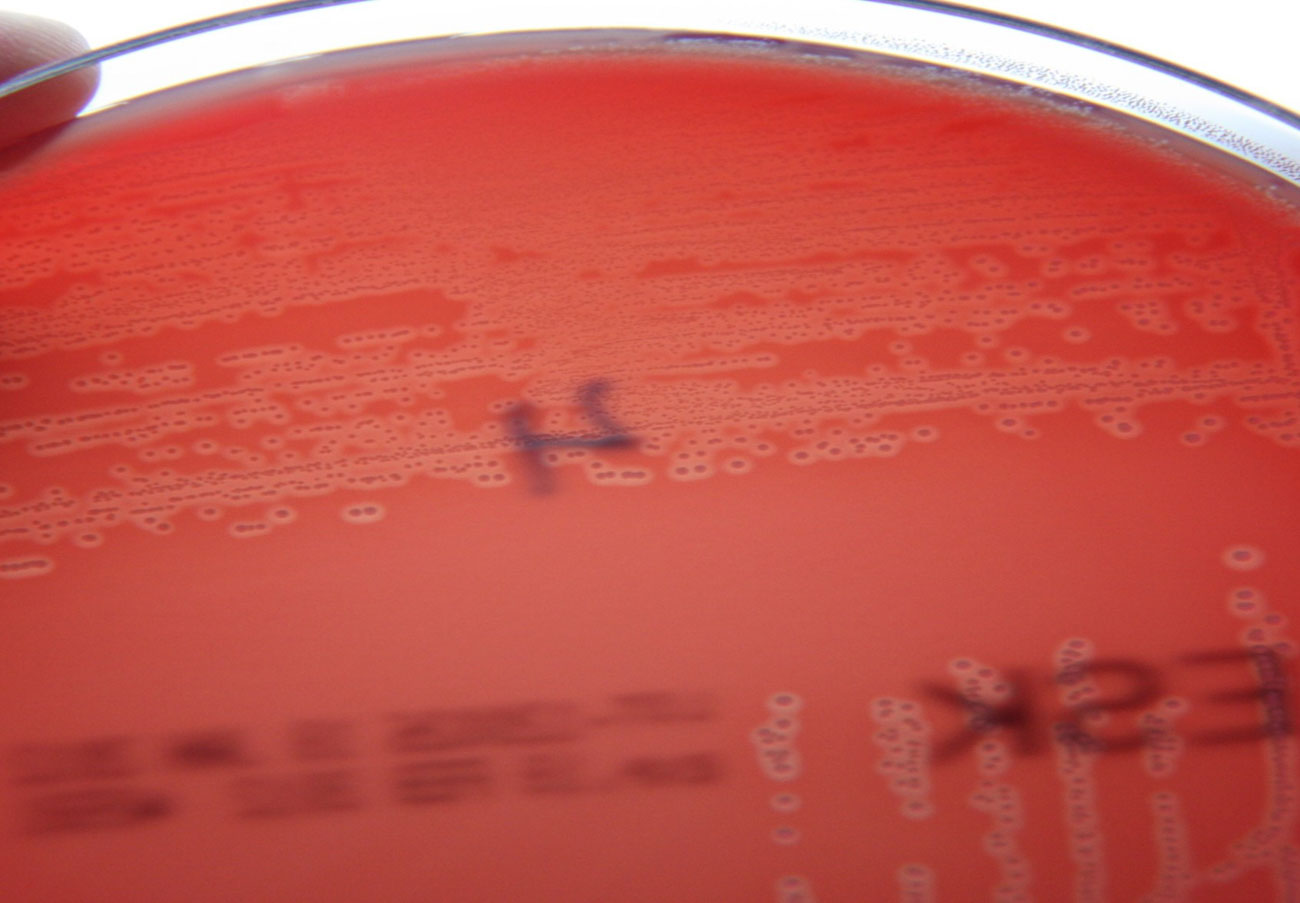

En heldag om Streptococcus agalactiae
Publicerades 2016-02-04
Onsdagen den 10 februari kommer SVA tillsammans med Växa Sverige att hålla ett seminarium – en hel dag som kommer ägnas enbart åt Streptococcus agalactiae-mastiter; klinik, förekomst, patogenes, riskfaktorer, diagnostik, behandling, sanering och förebyggande åtgärder.
Vi hoppas på en mycket givande dag med föreläsningar blandat med diskussioner om aktuella frågeställningar. Ser vi ett stort intresse kommer vi förhoppningsvis att kunna upprepa seminariet.
En rapport om de viktigaste punkterna på seminariet publicerar vi så klart här på Spjuverbloggen så snart vi kan efter det att seminariet har hållits.
På SVA:s webbplats kan du läsa mer om mastit orsakad av Streptococcus agalactiae hos nötkreatur.